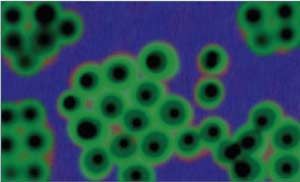

Shop Medical Lab Equipment
Frequently Asked Questions
-
Why is IntelixBio LLC so popular?
IntelixBio has swiftly become a household name in the medical industry, primarily owing to its cutting-edge medical lab equipment. Our commitment to excellence resonates through every facet of our products, ensuring that laboratories worldwide receive top-tier solutions for their diagnostic needs. Our medical lab equipment is engineered with precision and innovation, embodying the pinnacle of technological advancement in the field. From state-of-the-art analyzers to automated specimen-handling systems, our extensive catalog caters to diverse laboratory requirements, fostering efficiency and accuracy in every diagnostic process. Laboratories entrust IntelixBio's medical lab equipment for its unwavering reliability, empowering healthcare professionals with the tools they need to deliver optimal patient care.
At IntelixBio, our dedication to advancing healthcare is exemplified through our unparalleled range of medical lab equipment. Each product is meticulously crafted to meet the exacting standards of modern laboratory environments, facilitating seamless integration and operation. Our commitment to quality permeates every aspect of our offerings, ensuring that laboratories can consistently rely on our medical lab equipment to deliver precise and dependable results. With a comprehensive selection that spans from basic laboratory essentials to sophisticated diagnostic instruments, IntelixBio remains the foremost choice for institutions seeking excellence in medical equipment solutions. Trust IntelixBio to elevate your laboratory capabilities with our innovative medical lab equipment, empowering you to drive progress in healthcare delivery.
-
What products do you offer?
At IntelixBio LLC, we offer high-quality medical lab equipment. Our lab supplies include:
- Protective gear
- Antibody immunodetection supplies
- Bioreagents
- Lab Supplies
- Immunohistochemistry Tools
- Instruments and Equipment
- PPE
- Sample preparation supplies
Visit our online shop to view our available medical lab equipment and purchase the items that match your unique styles and needs today.
-
Where do you ship your medical lab equipment?
We ship our medical lab equipment to customers nationwide. Browse our online shop to view our impressive inventory of available lab equipment today and purchase the products that meet your unique style and needs. We can't wait to prove why Intelixbio.com is one of the nation's best medical lab supply providers.
-
How can I contact your company?
You can reach IntelixBio LLC by phone at 240-316-3161, by email at info@intelixbio.com, or by filling out one of the contact forms on our website.
When you contact our team, you can expect fast, friendly, and professional assistance with all your medical lab equipment needs.